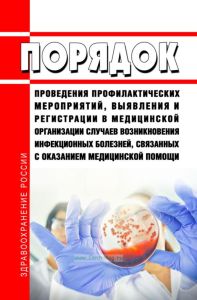
Порядок проведения профилактических мероприятий, выявления и регистрации в медицинской организации случаев возникновения инфекционных болезней, связанных с оказанием медицинской помощи 2025 год. Последняя редакция

- Артикул:00-01042102
- ISBN: 978-5-905080-97-5
- Обложка: Мягкая обложка
- Издательство: ЦЕНТРМАГ (все книги издательства)
- Город: Москва
- Страниц: 16
- Формат: А5 (148x210 мм)
- Год: 2026
- Вес: 21 г
- Серия: Приказы Минздрава (все товары серии)
Документ продается с актуализацией на дату продажи!
Приказ Минздрава России от 29.11.2021 N 1108н "Об утверждении порядка проведения профилактических мероприятий, выявления и регистрации в медицинской организации случаев возникновения инфекционных болезней, связанных с оказанием медицинской помощи, номенклатуры инфекционных болезней, связанных с оказанием медицинской помощи, подлежащих выявлению и регистрации в медицинской организации"
Содержание
Приказ Минздрава России от 29.11.2021 N 1108н "Об утверждении порядка проведения профилактических мероприятий, выявления и регистрации в медицинской организации случаев возникновения инфекционных болезней, связанных с оказанием медицинской помощи, номенклатуры инфекционных болезней, связанных с оказанием медицинской помощи, подлежащих выявлению и регистрации в медицинской организации"
Приложение N 1. Порядок проведения профилактических мероприятий, выявления и регистрации в медицинской организации случаев возникновения инфекционных болезней, связанных с оказанием медицинской помощи
Приложение. Информация о подозрении на случай инфекции (инфекционной болезни), связанной с оказанием медицинской помощи (Рекомендуемый образец)
Приложение N 2. Номенклатура инфекционных болезней, связанных с оказанием медицинской помощи, подлежащих выявлению и регистрации в медицинской организации